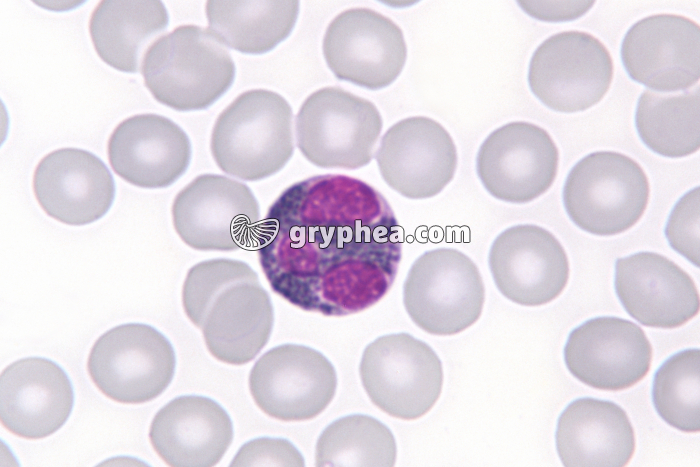
Granulocyte éosinophile x400 - gryphea.org

Les photographies, infographies, vidéos, sons et textes publiés sur ce site ne sont pas totalement libres de droits. Vous pouvez les utiliser librement à titre personnel, dans la création de vos cours, compte-rendus, diaporamas, en respectant le watermark qui y est inclus, à la condition expresse d'avoir souscrit à un abonnement. Le contrat d’utilisation ne vous autorise cependant pas à diffuser ces documents ailleurs que dans le cadre strict de votre enseignement, et en aucun cas sur les réseaux sociaux. Merci de votre compréhension.
Pour accéder à tous les contenus de gryphea.org, aux photos haute définition et aux vidéos intégrales, profitez de nos offres d'abonnement :
Le sang renferme et véhicule de nombreuses cellules appartenant au système immunitaire. Les principales d‘entre elles sont aisément reconnaissables sur un frottis sanguin observé à fort grossissement au microscope optique.
- les lymphocytes apparaissent sous la forme de petites cellules à noyau ovale, au cytoplasme rare
- les granulocytes ont une taille nettement plus grande, et se reconnaissent à leur noyau lobé ou irrégulier. Ils présentent des granulations plus ou moins visibles au sein de leur cytoplasme.
- les monocytes, ont un noyau globalement oblong ou en forme de grain de haricot.
La suite du commentaire est réservée aux abonnés